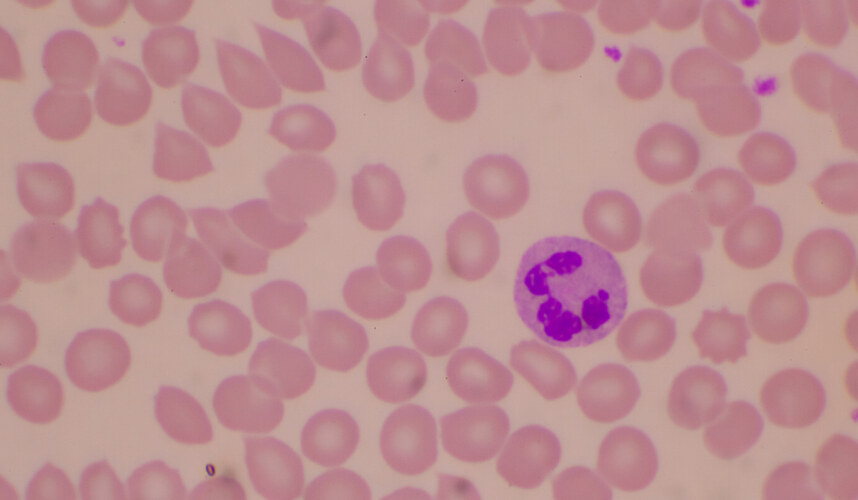

Akdeniz anemisi, hemoglobin üretiminde yer alan genlerdeki bozukluk nedeniyle ortaya çıkan kalıtsal bir kan bozukluğudur. Vücut yeterli miktarda sağlıklı kırmızı kan hücresi üretemediği için dokulara oksijen taşıma kapasitesi azalır. Bu durum enerji düşüklüğüne, cilt solgunluğuna ve nefes darlığına yol açabilir. Türkiye gibi Akdeniz coğrafyasında yaşayan toplumlarda taşıyıcı oranı oldukça yüksektir.
Kimlerde Görülür ve Kalıtım Nasıl Olur?
Bu durum otozomal resesif bir biçimde geçer. Eğer anne veya babadan biri taşıyıcıysa, genelde belirti olmaz. Ama her iki ebeveyn taşıyıcıysa çocukta hafif, orta veya ağır forma kadar değişen tablolar oluşabilir . Beta‑thalasemi majör formu (“Cooley anemisi”), hemoglobin beta zincirinin tamamen üretilemediği en ağır formdur .
Hangi Türleri Vardır?
Ana tipi beta‑talasemi olup, daha hafif alfa‑talasemi formları da vardır. Vücutta alfa ve beta zincirlerinin dengesinin bozulması sonucunda kırmızı kan hücreleri zamanla tahrip olur. Beta‑talasemi minor taşıyıcılık anlamına gelebilir; beta‑talasemi intermediate orta, major ciddi anemili formdur.
Akdeniz Anemisi Belirtileri Nelerdir?
En sık görülen belirtiler şu şekildedir:
- Sürekli yorgunluk, enerjisizlik, nefes darlığı
- Ciltte solgunluk, bazen hafif sararma (sarılık)
- Dalak büyümesi, kemik yapısında şekil değişikliği gibi gelişimsel etkiler olabilir
- Uzun dönemde demir birikimine bağlı kalp, karaciğer ve hormonal sorunlar ortaya çıkabilir
Nasıl Teşhis Edilir?
Tanı için yapılan testler şunlardır:
- Komple kan sayımı (hemoglobin, MCV, MCH gibi değerler) ve kan yayması incelemesi
- Hemoglobin elektroforezi veya HPLC gibi testlerle hangi alt form olduğu belirlenir
- DNA analizleriyle kesin gen mutasyonu saptanabilir
Bu testler özellikle evlilik öncesi veya hamilelik planı sırasında önerilir.
Talasemi Tedavisi ve Yönetimi Nasıl Olur?
Tedavi, hastalığın türüne göre değişir:
- Minor (hafif) form taşınıyor ise genelde düzenli tedavi gerekmez; doktor takibi yeterli olur.
- Intermediate veya major form varsa düzenli kan nakli gerekir; genelde her 3–5 haftada bir yapılır.
- Kan nakline bağlı demir birikimini önlemek için demir chelation tedavisi (örneğin deferoxamine, deferiprone, deferasirox) uygulanır.
- Folik asit gibi destekleyici vitamin önerilebilir.
- Bazı hastalar için uygun bir donörden kemik iliği nakli veya gen tedavisi seçenek olabilir; bu ileri düzey yaklaşımlarda kapsamlı değerlendirme gerekir.
Her durumda en doğru bilgi için doktoruna danışmalısın.
Nasıl Önlenir?
Talasemi taşıyıcılığı ancak genetik testlerle tespit edilebilir. Evlilik öncesi screening ve genetik danışma sayesinde hastalıklı çocuk doğma riski büyük ölçüde azaltılabilir. Kuzey Kıbrıs, Yunanistan ve Türkiye gibi bölgelerde uygulanan tarama programları bu açıdan modeldir.
Kaynaklar
- StatPearls, “Thalassemia is a heterogeneous group of blood disorders … ineffective erythropoiesis”
- Wikipedia, “Thalassemia” genel bilgi sayfası
- Wikipedia, “Beta‑thalassemia” (“Mediterranean anemia”) alt sayfası
- AAFP (American Academy of Family Physicians), “Alpha‑ and Beta‑thalassemia: Rapid Evidence Review”
- MDPI, “Thalassemia: Pathophysiology, Diagnosis, and Advances in Treatment” derlemesi
- PMC (National Institutes of Health), “Current status of beta‑thalassemia and its treatment strategies”